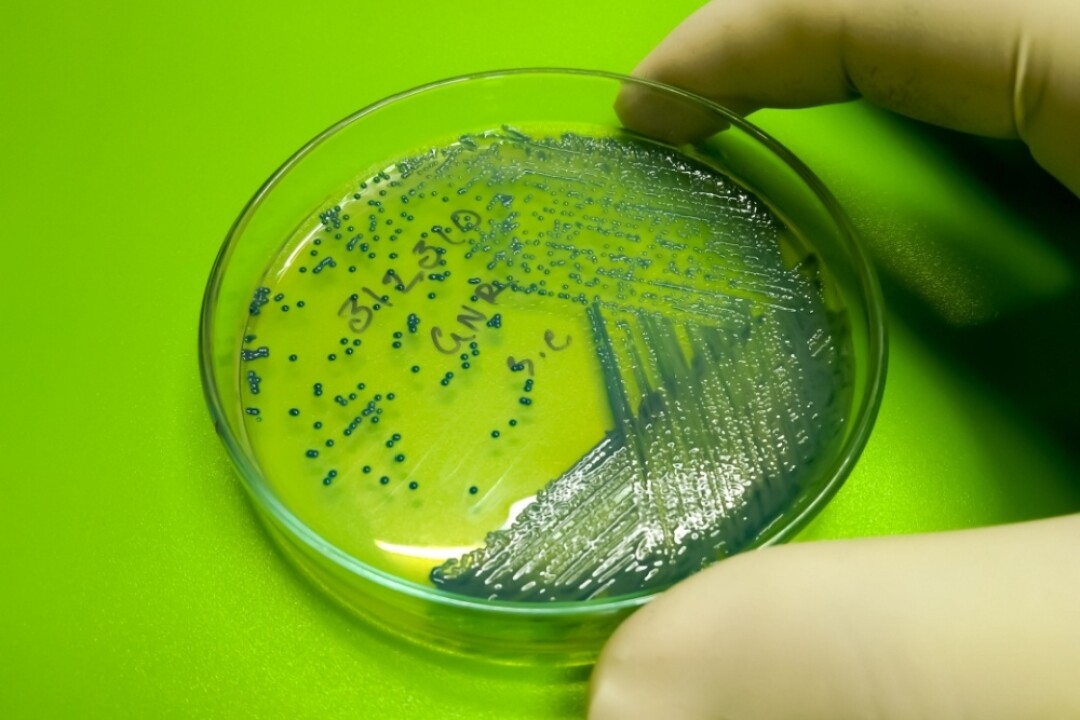

В середине октября ученые из Колумбийского университета заявили — ими созданы пробиотики, которые позволяют бороться с раковыми опухолями (как с первичными, так и с метастазами), не повреждая здоровые ткани организма. Исследователи уже отчитались об успешных испытаниях на мышах, а их статья опубликована в одном из важнейших научных журналах мира — Nature. Значит ли, что победа над раком уже близко? Или не стоит торопиться с выводами. Разбираемся в материале Собака.ru.
Что случилось?
«Взламываем бактерии для борьбы с раком», — текст с таким названием появился 16 октября на сайте Колумбийского университета (одного из престижнейших учебных и научных центров США). В сообщении указывалось, что ученые создали специальные бактерии, которые учат организм бороться с раковыми клетками.
Как утверждают авторы исследования, это «открывает двери перед появлением нового класса вакцин против рака». Такие препараты, если верить ученым, можно персонифицировать, исходя из потребностей конкретного пациента. Сообщается, что разработанные бактерии можно использовать «для борьбы как с первичной опухолью, так и для борьбы с метастазами», а также «для предупреждения рецидивов».
Сообщается, что работу бактерий уже успешно проверили на мышах. «В итоге [мы увидели, что] бактериальная вакцина способна контролировать или устранять рост первичных или метастатических опухолей и увеличивать выживаемость в мышиных моделях», — цитирует сайт университета одного из авторов исследования Чонвона Има.
Научная статья ученых, с описанием бактерий и их исследования на грызунах опубликована в тот же день, 16 октября, в одном из ведущих научных журналов мира Nature.
Как это работает?
В основе метода, который предложили ученые Колумбийского университета лежат бактерии Escherichia coli Nissle 1917. Фармацевтические компании часто используют их для создания разного рода пробиотиков.
Для того, чтобы превратить бактерию в средство для борьбы с раком, ученые Колумбийского университета повергли их целому ряду генетических модификаций. Главная из них — наделение кишечной палочки возможностью нести на себе так называемые неоантигены, то есть особые вещества (пептиды), которые образуются на поверхности раковых клеток. Еще одно важное изменение — ученые отключили у Escherichia coli присущее ей свойство избегать иммунного ответа организма.
После введения такие модифицированные Escherichia coli вызвать сильную реакцию — организм начнет бороться с попавшими в него микроорганизмами. А поскольку они будут нести в себе неантигены, то заодно организм начнет уничтожать все раковые клетки, на поверхности которых будет присутствовать те же пептиды. При этом, поскольку на поверхности здоровых клеток, этих неоантигенов нет, то здоровые ткани пострадать не должны.
Предполагается, что в будущем, набор неоатигенов будет подбираться индивидуально — врачи будут изучать, какие именно неоантигены содержатся в клетках опухоли пациента. «Время лечения будет зависеть в первую очередь от того, сколько времени потребуется для секвенирования (определения состав белков, — прим. Собака.ru) опухоли. Затем нам просто нужно будет создать бактериальные штаммы [содержащие соответствующие неоантигены], что может быть довольно быстро», — приводит сайт Колумбийского университета объяснение одного из соавторов исследования Тала Данино.
При этом, отмечают в университете, бактерии могут нести сразу несколько неоантигенов, таким образом, раковым клеткам будет сложно уклоняться от реакции иммунитета, мутируя и «избавляясь» от одного из них. Кроме того, поскольку организм в целом учится «бить» по клеткам с такими пептидами, то иммунитет начинает бороться не только с исходной опухолью, но и с ее метастазами. «После активации бактериальной вакциной иммунная система будет вынуждена уничтожать раковые клетки, которые распространились по всему организму», — говорится в сообщении Университета.
Что известно об эффективности?
Исследователи провели серию экспериментов на мышах, больных коллатеральным раком и меланомой. В первом случае даже однократное введение препарата с бактериями непосредственно в опухоль, приводило к «контролю и полной регрессии» двух из шести новообразований, говорится в статье в журнале Nature.
Внутривенная терапия при коллатеральном раке показала еще большую эффективность: «после внутривенной инъекции сконструированные микробы сохранялись с высокой плотностью внутри опухолей и быстро выводились из всех других обследованных органов», — говорится в тексте статьи. В итоге спустя 45 дней, все проходившие такое лечение мыши были живы, в то время как контрольная группа больных грызунов погибла от болезни.
В случае с меланомой, лечение также значительно повысило выживаемость, отмечают авторы в своей статье. Для разных типов заболевания были разработаны семь препаратов, каждый из которых содержал шесть уникальных антигенов, характерных для конкретного типа опухолей. При внутривенном лечении 72% мышей «были живы через 50 дней после [начала лечения], тогда как все мыши контрольной группы погибли от злокачественного новообразования к 24 или 30 дню», — говорится в статье.
Также в тексте для Nature ученые указывают успех в борьбе с метастазами. «60% мышей прожили до 55 дней [после старта лечения] без обнаруживаемых метастазов, тогда как все мыши контрольной группы умерли к 27 дню», — констатируют авторы исследования. При этом они подчеркивают, что всякий раз лечение переносилось легко и не вызывало значимой потери веса у животных.
Это правда прорыв?
Вскоре после появления релиза от Колумбийского университета, в медиа, в том числе русскоязычных, появились сообщения об «ошеломляющем прорыве» в поисках средства от рака и о том, что ученые уже «создали вакцину против рака». Однако врач-онколог сети клиник Lahta Clinic Шейла Кучаева в беседе с редакцией Собака.ru высказала более осторожные оценки.
По ее словам, попытки разработать препарат, который бы активировал бы естественный противоопухолевый иммунитет не новы. «Неоднократно проводились исследования, в частности для лечения рака поджелудочной железы и меланомы, в которых ученые пытались создать эффективные вакцины нацеленные на опухолевые антигены, — говорит собеседница редакции. — Так, противоопухолевая вакцина на основе живых вирусов T-VEC (относятся к модифицированным генетическим путем вирусам) зарегистрирована FDA в 2015 году для лечения метастатической меланомы. В целом, концепт переноски "лекарства от рака" (в данном случае вакцины) также известен давно. Проблема в том, что не со всеми опухолями можно справиться таким способом».
Шейла Кучаева
Врач-онколог сети клиник Lahta Clinic:
Как практическому онкологу, мне всегда радостно видеть новости о новых методах. Но все подобные открытия проходят проверку на «выживаемость» на практике, где важно, чтобы метод был недорогой, легко воспроизводимый, эффективный при применении у людей (то есть прошел все клинические исследования) и самое главное безопасный. Без этих данных, «ошеломляющий» остается лишь словом в новостной ленте. В данном исследовании, оценка проводилась лишь на лабораторных мышах.
При этом, отметила собеседница редакции, напомнила, что в журналах уровня Nature публикуются данные, «действительно заслуживающие внимания». «Вакцины остаются перспективным методом лечения рака, так что будем и дальше следить на научными открытиями, но не отрываясь от реальности», — добавляет она.
А если разработка пройдет проверку на «выживаемость», когда оно может попасть в больницы?
«Мы приближаемся к моменту тестирования этой терапии на пациентах», — приводит университет слова еще одного соавтора исследования Николаса Арпайи. Из этого можно сделать вывод о том, что препарат может быть опробован на людях уже в обозримом будущем.
Однако, напоминает в беседе с Собака.ru Шейла Кучаева из Lahta Clinic, к подобным заявлениям следует относиться осторожно. «Доклинические исследования (как описанное в статье Колумбийского университета) могут длиться очень долго, пока не появятся четкие результаты об эффективности и безопасности метода. Только при получении хороших результатов, начинается этап клинических исследований на людях, которые состоят их 3 этапов, каждый из которых может занять 3–5 и более лет», — констатирует собеседница редакции.

Комментарии (0)